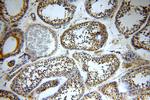
TXNRD3 Antibody in Immunohistochemistry (Paraffin) (IHC (P))

Search
Proteintech
TXNRD3 Polyclonal Antibody
{{$productOrderCtrl.translations['antibody.pdp.commerceCard.promotion.promotions']}}
{{$productOrderCtrl.translations['antibody.pdp.commerceCard.promotion.viewpromo']}}
{{$productOrderCtrl.translations['antibody.pdp.commerceCard.promotion.promocode']}}: {{promo.promoCode}} {{promo.promoTitle}} {{promo.promoDescription}}. {{$productOrderCtrl.translations['antibody.pdp.commerceCard.promotion.learnmore']}}
产品信息
19517-1-AP
种属反应
宿主/亚型
分类
类型
抗原
偶联物
形式
浓度
规格
纯化类型
保存液
内含物
保存条件
运输条件
靶标信息
Displays thioredoxin reductase, glutaredoxin and glutathione reductase activities. Catalyzes disulfide bond isomerization. Promotes disulfide bond formation between GPX4 and various sperm proteins and may play a role in sperm maturation by promoting formation of sperm structural components.
仅用于科研。不用于诊断过程。未经明确授权不得转售。
生物信息学
蛋白别名: selenoprotein TXNRD3; Thioredoxin and glutathione reductase; thioredoxin glutathione reductase; thioredoxin reductase 2 intronic transcript 1; Thioredoxin reductase 3; Thioredoxin reductase 3 intronic transcript 1; Thioredoxin reductase 3 neighbor gene; thioredoxin reductase 3 neighbor gene protein; thioredoxin reductase 3 new transcript 1; Thioredoxin reductase TR2; txnrd3; TXNRD3 neighbor gene protein; unnamed protein product
基因别名: AI196535; TGR; TR2; TR2IT1; TRXR3; TXNR3; TXNRD3; TXNRD3IT1; TXNRD3NB; TXNRD3NT1
UniProt ID: (Human) Q86VQ6, (Mouse) Q99MD6
Entrez Gene ID: (Human) 114112, (Rat) 297437, (Mouse) 232223